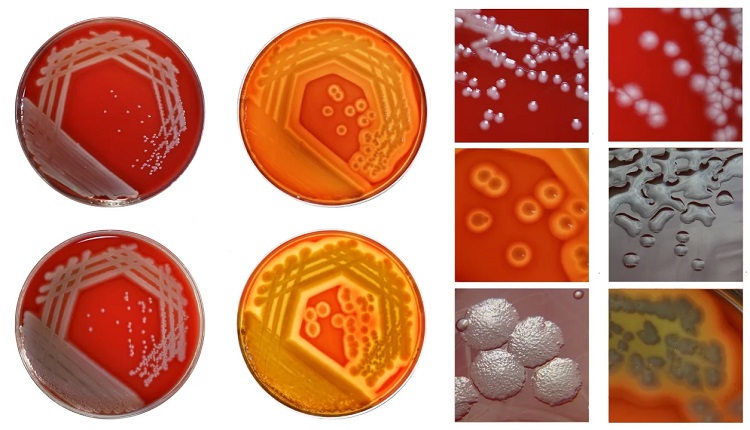
انواع باکتری های کشت زخم کدامند

کشت زخم و روش های آن

کشت زخم یک آزمایش مخبری است که برای تشخیص و شناسایی باکتریهای بیماریزا در یک زخم استفاده میشود. در این روش، نمونهای از ترشحات زخم (مثلاً از طریق گرفتن پلاکهای از زخم) در یک محیط مناسب جمعآوری میشود و سپس در شرایط مناسب کشت داده میشود.
محیط کشت، محیطی است که شرایط مناسب برای رشد و تکثیر باکتریها فراهم میکند. در آزمایش کشت زخم، نمونههای ترشحات زخم در محیط کشت قرار میگیرند و سپس به مدت معینی در دما و رطوبت مناسب کشت میشوند. در طی این دوره، باکتریهای موجود در نمونه رشد میکنند و باعث ایجاد کلونیهای قابل رؤیت در محیط کشت میشوند.
سپس، کلونیهای باکتریای که رشد کردهاند، مورد بررسی قرار میگیرند. این کلونیها میتوانند تحت مجهرهای مختلف مانند رنگآمیزی گرم، رنگ زنی گرم، یا آزمونهای بیوشیمیایی برای شناسایی دقیقتر باکتریها مورد بررسی قرار گیرند.
با استفاده از نتایج کشت زخم، میتوان نوع باکتریهای موجود در زخم را شناسایی کرده و به پزشک درمان زخم اطلاعات لازم برای تشخیص و درمان مناسب بیماری فراهم کرد. این آزمایش میتواند به پزشک کمک کند تا درمان مناسب و موثرتری را برای زخم ارائه دهد.

فهرست موضوعات
آزمایش های کشت زخم چگونه انجام میشود
گرفتن نمونه از زخم: ابتدا پزشک یا پرستار نمونهای از ترشحات زخم را جمعآوری میکند. این ممکن است با استفاده از سوابق یا تکنیکهای مختلف مثل گرفتن پلاکهای از زخم یا استفاده از شانههای نمونهبرداری انجام شود.
آمادهسازی نمونه: نمونههای جمعآوری شده به طور کامل در محیط مناسب حفظ میشوند تا به آزمایشگاه منتقل شوند. این محیط ممکن است شامل محیطهای کشت مخصوص باکتریها باشد.
کشت نمونه در آزمایشگاه: نمونهها به آزمایشگاه منتقل میشوند و در محیطهای کشت قرار میگیرند. محیطهای کشت معمولاً شامل محیطهایی هستند که شرایط مثل دما، رطوبت، و مواد تغذیه مناسبی برای رشد باکتریها فراهم میکنند.
رصد و نظارت بر رشد باکتریها: نمونهها تحت نظارت و رصد مداوم قرار میگیرند تا رشد باکتریها در آنها مشاهده شود. این میتواند به مدت چند روز تا چند هفته طول بکشد.
تشخیص و شناسایی باکتریها: پس از رشد کلونیهای باکتری در محیط کشت، آنها تحت مجهرها و آزمونهای مختلفی مانند آزمونهای بیوشیمیایی یا آزمونهای مولکولی برای شناسایی و تعیین نوع باکتریها قرار میگیرند.
گزارش نتایج: پس از شناسایی و تشخیص باکتریهای موجود در نمونه، نتایج به پزشک ارائه میشود تا بتواند تشخیص دقیقتری برای بیماری بگذارد و درمان مناسب را تجویز کند.همه این مراحل با دقت و تحت نظارت صحیح انجام میشوند تا نتایج آزمایش کشت زخم معتبر و قابل اعتماد باشد.

انواع کشت زخم
انواع مختلفی از کشت زخم وجود دارند، که هر کدام برای موارد خاصی از زخمها مناسب هستند. این انواع شامل موارد زیر میشوند:
کشت سوآب : در این روش، یک سوآب از ترشحات زخم با استفاده از یک سواب گرفته میشود و سپس در محیط کشت مناسب قرار میگیرد. این روش معمولاً برای زخمهایی که ترشحات زیادی دارند و ممکن است باعث عفونت شوند، استفاده میشود.
بیوپسی بافت عمیق : در بعضی موارد، نمونهای از بافت عمیق زخم برای کشت گرفته میشود تا باکتریها و عفونتها در بافت عمیق نیز شناسایی شوند. این روش معمولاً برای زخمهای عمیق و گسترده، یا زخمهایی که عفونت در بافت عمیق مشکوک است، استفاده میشود.
کشت سوزنی : در این روش، با استفاده از یک سوزن، نمونهای از مایعات یا ترشحات زخم گرفته میشود و سپس در محیط کشت مناسب قرار میگیرد. این روش معمولاً برای زخمهایی که ممکن است عفونت در مایعات زخم وجود داشته باشد، مورد استفاده قرار میگیرد.
هر یک از این روشها ممکن است برای شناسایی باکتریها و عفونتهای مختلف در زخمها مفید باشند، و انتخاب روش مناسب بستگی به وضعیت خاص زخم و نیازهای بالینی بیمار دارد.
چه زخم هایی به کشت نیاز دارند
کشت زخم معمولاً برای زخمهایی که تشخیص و درمان مناسبی برای آنها مشکل است یا عفونت زخم مشکوک است، نیازمند است. زیرا در این زخمها، تشخیص دقیق و شناسایی باکتریهای موجود میتواند به پزشک کمک کند تا درمان مناسب و موثرتری را تجویز کند. برخی از زخمهایی که ممکن است به کشت نیاز داشته باشند، عبارتند از:
زخمهای عمیق: زخمهایی که عمق زیادی دارند و ممکن است باکتریهای مختلفی در عمق زخم رشد کنند، به کشت نیاز دارند.
زخمهای باعث ناراحتیهای شدید: زخمهایی که علائم عفونتی مانند قرمزی، گرمایی، درد شدید و یا تورم دارند، نیازمند بررسی دقیقتر با استفاده از کشت هستند.
زخمهای تروماتیک: زخمهای ناشی از تروما یا آسیب دیدگی، به ویژه زخمهای باز، ممکن است بیشترین احتمال عفونت را داشته باشند و نیازمند کشت جهت تشخیص عفونت باشند.
زخمهای قدیمی یا مزمن: زخمهایی که مدت زمان طولانیتری از زمان ایجادشان گذشته است و به دلیل مواردی مانند زخم مزمن یا ضعف سیستم ایمنی بدن، عفونت شدید ممکن است، نیازمند بررسی دقیق با کشت هستند.
زخمهای شایع: زخمهایی که بیشترین احتمال برای ابتلا به عفونت دارند مانند زخمهای بستری (بستر زخم) و زخمهای دیابتی.در هر صورت، تصمیم نهایی در مورد انجام آزمایش کشت زخم بستگی به ارزیابی پزشک و وضعیت خاص زخم و بیماری دارد.

انواع باکتریهای کشت زخم
در زخمها ممکن است باکتریهای مختلفی رشد کنند. این باکتریها معمولاً به دو دسته عمده تقسیم میشوند: باکتریهای معمول و باکتریهای بیماریزا. برخی از باکتریهای معمول که ممکن است در کشت زخم دیده شوند عبارتند از:
Staphylococcus aureus: یکی از شایعترین باکتریهای موجود در زخمها، ممکن است باعث عفونتهای جدی مانند عفونتهای خون، عفونتهای پوستی، و عفونتهای استخوان شود.
Streptococcus pyogenes: این باکتری نیز معمولاً در زخمها یافت میشود و ممکن است باعث عفونتهای پوستی و عفونتهای تنفسی شود.
Pseudomonas aeruginosa: این باکتری اغلب در زخمهای خارجی و محیطهای مرطوب و رطوبتی یافت میشود و میتواند عفونتهای جدی مانند سوپوراتیون زخم (عفونت زخم) را ایجاد کند.
Enterococcus faecalis: این باکتری نیز معمولاً در زخمها یافت میشود و ممکن است عفونتهای جدی مانند عفونتهای ادراری و عفونتهای خون را ایجاد کند.
Escherichia coli : این باکتری معمولاً در زخمهای ناشی از آلودگی به مدفوع یافت میشود و ممکن است باعث عفونتهای گوارشی و ادراری شود.
Acinetobacter baumannii: این باکتری معمولاً در زخمهای بستری (بستر زخم) یافت میشود و ممکن است باعث عفونتهای بیمارستانی جدی شود.
Clostridium perfringens: این باکتری ممکن است در زخمهای عمیق و زخمهایی که بافتهای عمیق را تخریب کرده باشند، یافت شود و ممکن است باعث عفونتهای جدی مانند گانگرن (انحلال بافت) شود.
این فهرست تنها یک نمونه از باکتریهایی است که ممکن است در زخمها دیده شوند، و هر زخم ممکن است باکتریهای مختلفی داشته باشد که نیازمند بررسی دقیق و شناسایی باشند.

نکات مهم در هنگام نمونه گیری از زخم
این نکات بسیار مهم و حیاتی در نمونهگیری از زخمها هستند. برای اطمینان از دقت و صحت نمونهگیری، این موارد را باید در نظر گرفت:
قبل از شستشوی زخم: اگر زخم به طور مداوم شستشو میشود، نمونه باید قبل از هرگونه شستشو و ضدعفونی شدن محل زخم گرفته شود تا بتوان باکتریها را در شرایط طبیعی زخم شناسایی کرد.
پاکسازی از پمادهای آنتیبیوتیک: در صورت استفاده از پمادهای آنتیبیوتیک، محل زخم باید کاملاً پاکسازی شود تا باکتریهای موجود در زخم بدون موانعی قابل شناسایی باشند.
اطلاع از داروهای مصرفی بیمار: اگر بیمار قبل از نمونهبرداری از داروهای خاصی استفاده کرده است، این اطلاعات باید به مسئولین آزمایشگاه ارائه شود، زیرا ممکن است داروها تأثیری بر نتایج آزمایش داشته باشند.
زمان مناسب برای ارسال نمونه: نمونه باید در اسرع وقت به آزمایشگاه ارسال شود تا به نحو صحیح و به موقع مورد بررسی قرار گیرد.
نگهداری مناسب نمونه: نمونه باید در شرایط مناسب نگهداری شود تا بهترین نتیجه را ارائه دهد. این شامل دوره زمانی نگهداری و دمای مناسب است.
ظرف استریل: نمونه باید در یک ظرف کاملاً استریل جمعآوری و نگهداری شود تا هیچ آلودگی خارجی به آن نفوذ نکند.
اطلاعات دقیق بر روی نمونه: هر نمونه باید با اطلاعات کامل و دقیق مثل نام بیمار، شماره پرونده پزشکی، تاریخ و زمان نمونهگیری و غیره تجهیز شود تا هیچ اشتباهی در نمونهگیری و آزمایش ندهد.رعایت این نکات به طور کامل، میتواند به دقت و صحت نمونهگیری و نتایج آزمایش کشت زخم کمک کند.

انجام کشت زخم چه اهمیت و مزایایی دارد
تشخیص دقیق عفونت: کشت زخم به پزشکان کمک میکند تا با دقت بیشتری باکتریهای موجود در زخم را شناسایی و تشخیص دهند. این کار به تشخیص دقیقتر عفونت و انتخاب بهتر درمان مناسب کمک میکند.
انتخاب درمان مناسب: با شناسایی باکتریهای موجود در زخم، پزشکان میتوانند داروهای ضدباکتریایی را با دقت بیشتری انتخاب کنند و درمانی را که بهترین نتیجه را برای بیمار به ارمغان میآورد، تجویز کنند.
کنترل عفونت: با شناسایی عفونت و باکتریهای موجود در زخم، پزشکان میتوانند برنامههای مناسبی برای کنترل و درمان عفونت را تدوین کنند، که این موضوع میتواند به بهبودی سریعتر زخم و پیشگیری از عوارض جدی مربوط به عفونت کمک کند.
پیگیری و رصد درمان: با انجام کشت زخم، پس از شروع درمان، میتوان با مانیتورینگ و رصد مداوم عفونت و باکتریها، اثربخشی درمان را ارزیابی کرد و در صورت نیاز، تغییراتی در برنامه درمانی اعمال کرد.
کاهش مقاومت دارویی: شناسایی دقیق باکتریها و انتخاب داروهای مناسب باعث میشود که مصرف غیرضروری آنتیبیوتیکها کاهش یابد، که این امر میتواند به کاهش مقاومت دارویی باکتریها کمک کند.
با کلیه این مزایا، انجام کشت زخم به عنوان یک ابزار مهم و کارآمد در تشخیص و درمان زخمها و عفونتهای مرتبط با آنها در نظام بهداشت و درمان اهمیت زیادی دارد.